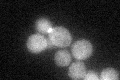
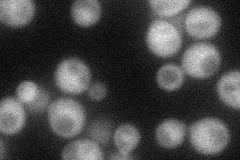
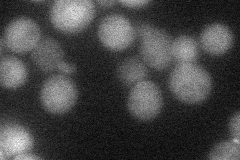
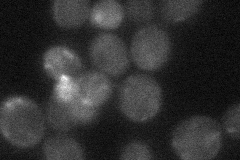
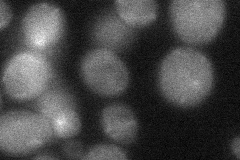
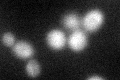
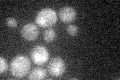

View description
Component of the RAM signaling network, that activates the Cbk1p kinase, thereby facilitating the Ace2p-dependent daughter cell-specific transcription of genes involved in cell separation; similar to Mob1p
Localization:
Intensity:
Fold change:
Significance:
-
C’ GFP library in SD
cytosol:bud neckN/A -
N' NOP1pr-GFP in SD
cytosol,bud neck38.0513 -
N' TEF2pr-mCherry in SD
bud neck18.4338 -
N' NATIVEpr-GFP in SD
bud neck22.8928 -
N' TEF2pr-VC and Cyto-VN in SD
cytosol30.6619 -
C’ GFP library in SD+DTT
cytosol.bud neck27.660.96No -
C’ GFP library in SD+H2O2

cytosol.bud neck28.971No -
C’ GFP library in Starvation Media
cytosol,bud neck19.70.68Yes -
C’ GFP library on the background of Pup2-DaMP

cytosol:bud neck -
C’ GFP library on the background of CCT mutant

cytosol:bud neck27.64890.963556No
